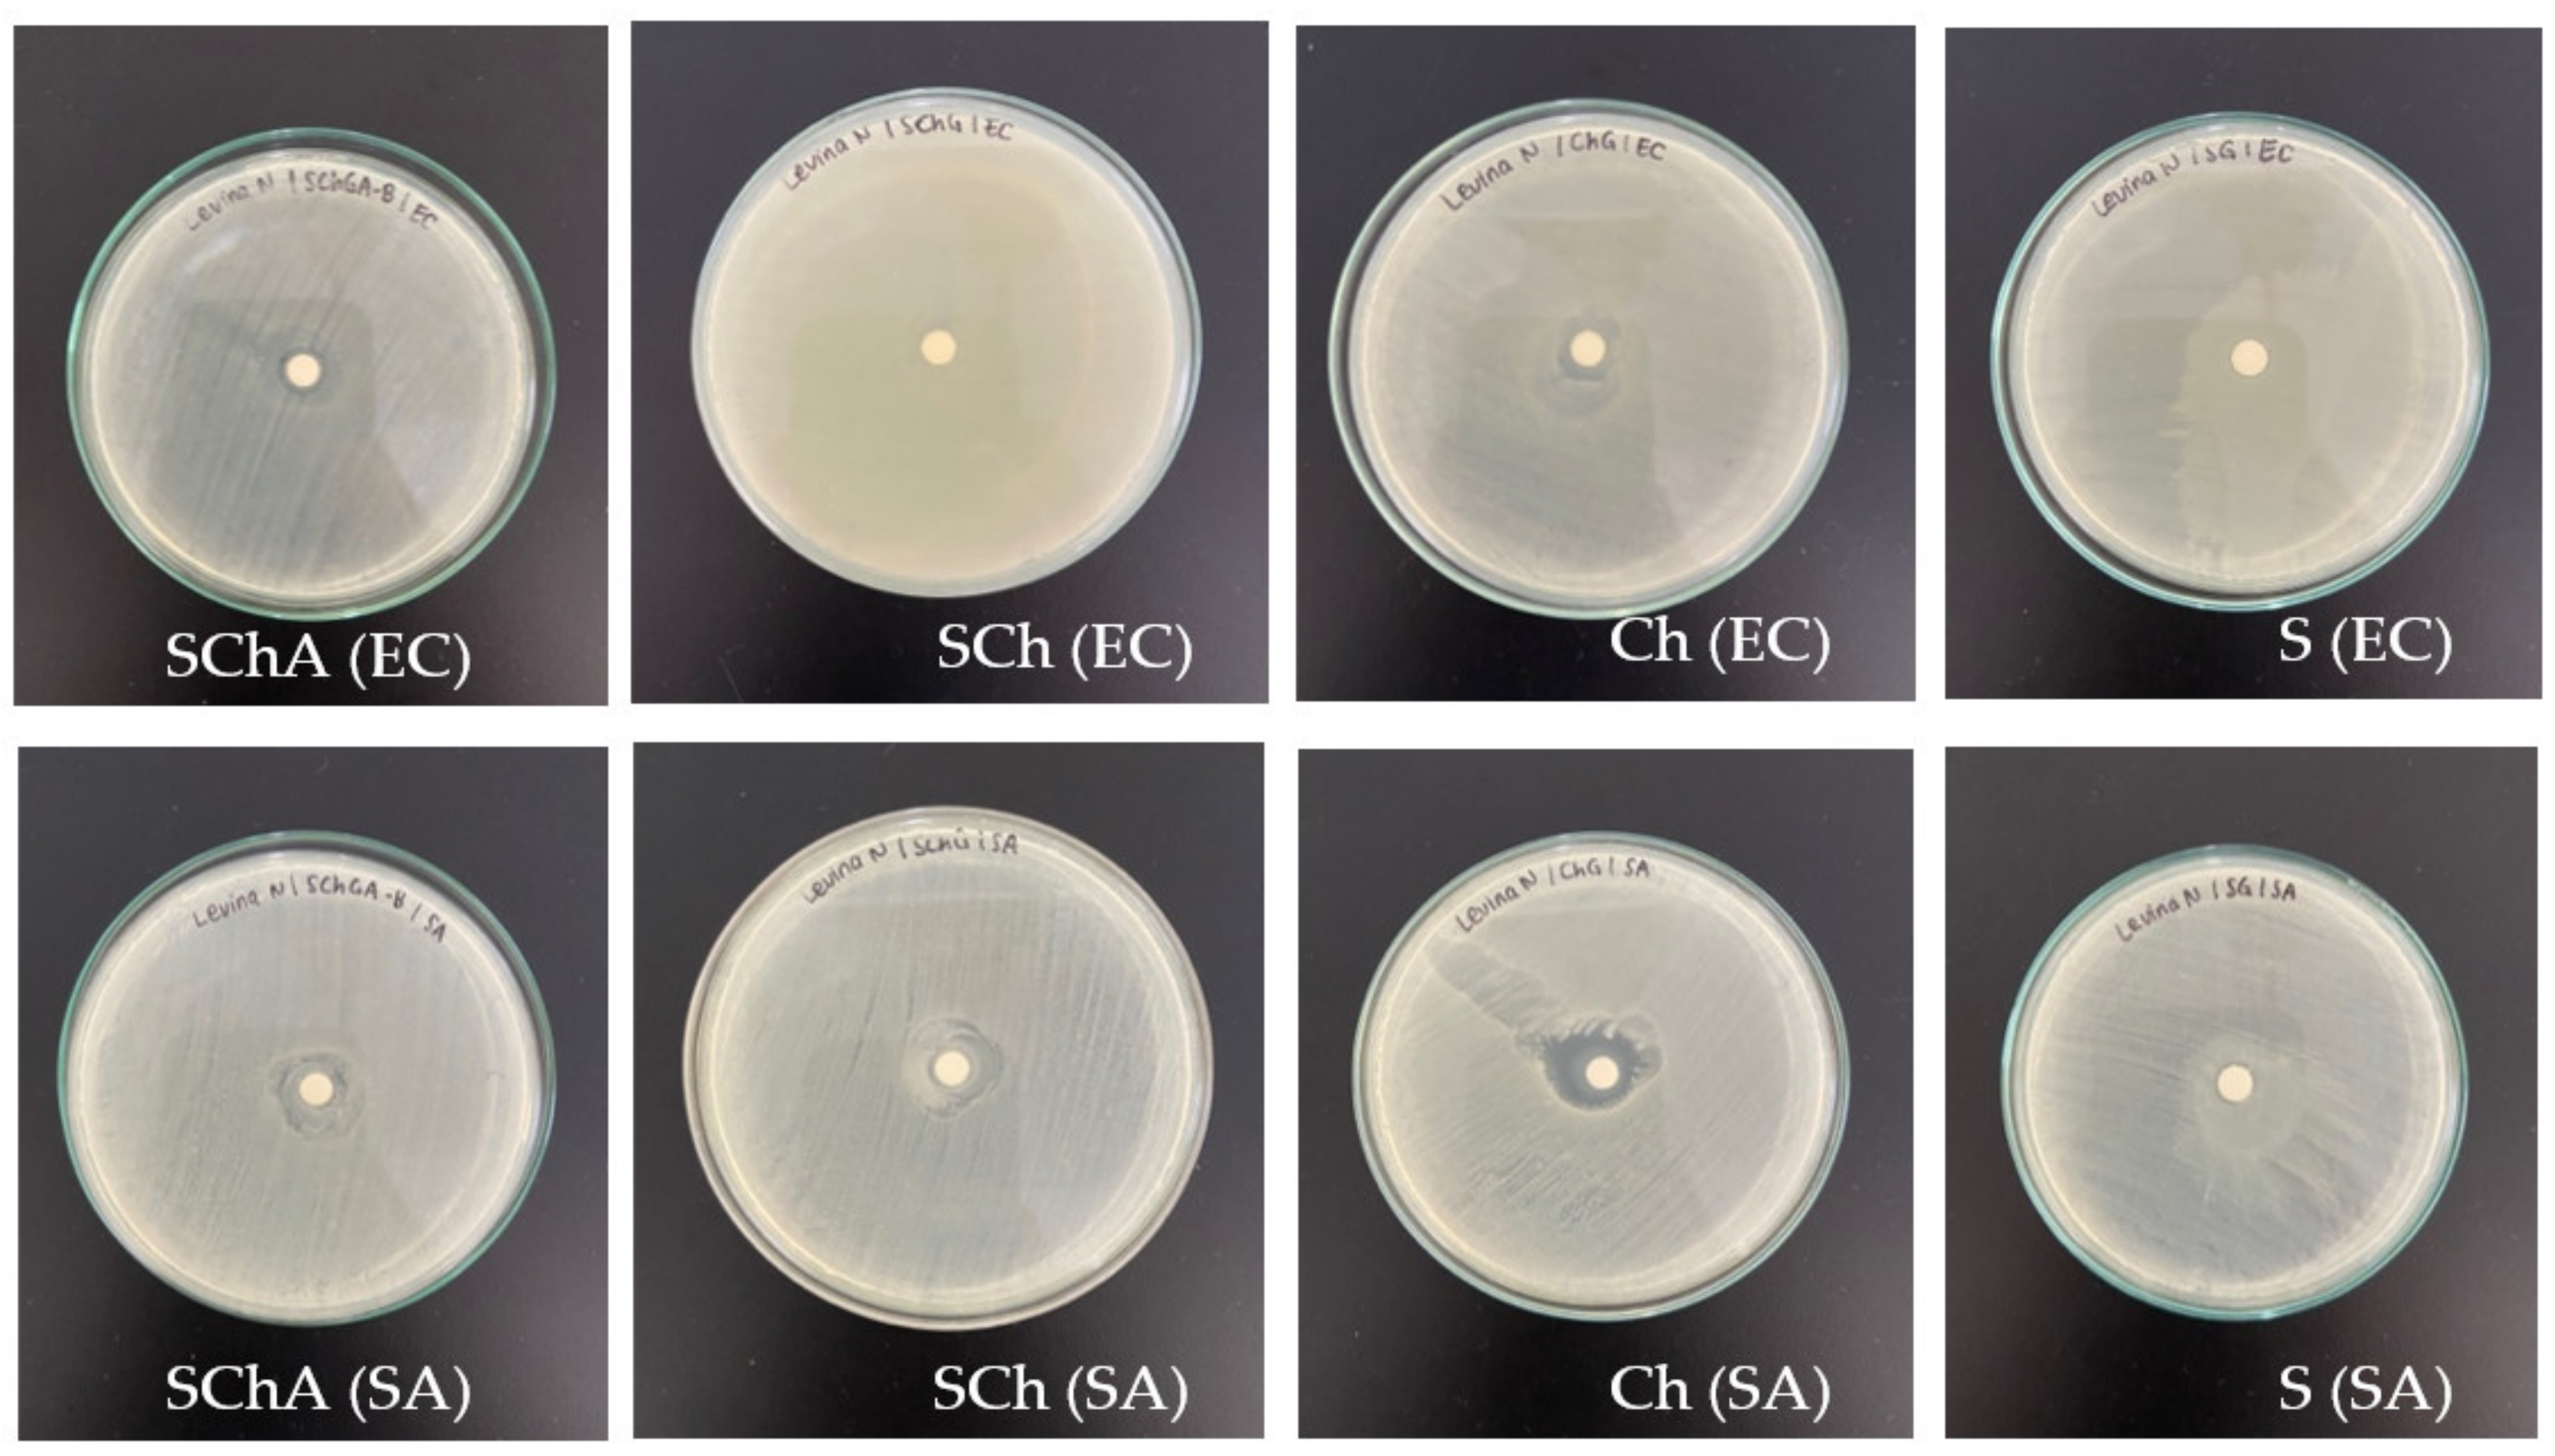
Polymers 14 04142 g007 Polymers 14 04142 g007

Development of an Indicator Film Based on Cassava Starch–Chitosan Incorporated with Red Dragon Fruit Peel Anthocyanin Extract
Abstract
1. Introduction
2. Materials and Methods
2.1. Materials
2.2. Methods
2.2.1. Extraction of Anthocyanin from the Red Dragon Fruit Peel
2.2.2. Analysis of Total Anthocyanin Content of the Extract
2.2.3. Analysis of the Color Change of the Extract in Various pH Conditions
2.2.4. Preparation of the Films
2.2.5. Composite Film Casting
2.2.6. Measurement of Thickness and Mechanical Properties
2.2.7. Composite Films’ Surface Color Analysis
2.2.8. Sensitivity Analysis of Indicator Film to Ammonia Vapor
2.2.9. Sensitivity Analysis of the Indicator Film to Various pH Conditions
2.2.10. Morphology Analysis of Composite Films
2.2.11. Transparency Analysis
2.2.12. Analysis of Antioxidant Activity
2.2.13. Analysis of Antimicrobial Activity
2.2.14. Shrimp Freshness Monitoring
2.2.15. Statistical Analysis
3. Results
3.1. Color Change of the Red Dragon Fruit Peel Extract
3.2. Composite Films
3.3. Thickness and Mechanical Properties of Composite Films
3.4. Surface Color of Composite Films
3.5. Sensitivity of Indicator Film to Ammonia Vapor
3.6. Sensitivity of Indicator Film in Different pH Conditions
3.7. Surface Morphology of Composite Films
3.8. Transparency of Composite Films
3.9. Antioxidant Activity
3.10. Antimicrobial Activity
3.11. Shrimp Freshness Monitoring
4. Discussion
5. Conclusions
Author Contributions
Funding
Institutional Review Board Statement
Data Availability Statement
Acknowledgments
Conflicts of Interest
References
- Salgado, P.R.; di Giorgio, L.; Musso, Y.S.; Mauri, A.N. Recent Developments in Smart Food Packaging Focused on Biobased and Biodegradable Polymers. Front. Sustain. Food Syst. 2021, 5, 125. [Google Scholar] [CrossRef]
- Chen, S.; Brahma, S.; Mackay, J.; Cao, C.; Aliakbarian, B. The role of smart packaging system in food supply chain. J. Food Sci. 2020, 85, 517–525. [Google Scholar] [CrossRef] [PubMed]
- European Commission. European Commission Regulation No. 450/2009 of 29 May 2009 on active and intelligent materials and articles intended to come into contact with food. Off. J. Eur. Union 2009, 38, 214–222. Available online: https://eur-lex.europa.eu/legal-content/EN/ALL/?uri=CELEX%3A32009R0450 (accessed on 13 September 2022).
- Priyadarshi, R.; Ezati, P.; Rhim, J.W. Recent Advances in Intelligent Food Packaging Applications Using Natural Food Colorants. ACS Food Sci. Technol. 2021, 1, 124–138. [Google Scholar] [CrossRef]
- Pirsa, S.; Sani, I.K.; Khodayvandi, S. Design and fabrication of starch-nano clay composite films loaded with methyl orange and bromocresol green for determination of spoilage in milk package. Polym. Adv. Technol. 2018, 29, 2750–2758. [Google Scholar] [CrossRef]
- Drago, E.; Campardelli, R.; Pettinato, M.; Perego, P. Innovations in smart packaging concepts for food: An extensive review. Foods 2020, 9, 1628. [Google Scholar] [CrossRef]
- Roy, S.; Kim, H.J.; Rhim, J.W. Effect of blended colorants of anthocyanin and shikonin on carboxymethyl cellulose/agar-based smart packaging film. Int. J. Biol. Macromol. 2021, 183, 305–315. [Google Scholar] [CrossRef]
- Weston, M.; Phan, M.A.T.; Arcot, J.; Chandrawati, R. Anthocyanin-based sensors derived from food waste as an active use-by date indicator for milk. Food Chem. 2020, 326, 127017. [Google Scholar] [CrossRef]
- Rawdkuen, S.; Faseha, A.; Benjakul, S.; Kaewprachu, P. Application of anthocyanin as a color indicator in gelatin films. Food Biosci. 2020, 36, 100603. [Google Scholar] [CrossRef]
- Choi, I.; Lee, J.Y.; Lacroix, M.; Han, J. Intelligent pH indicator film composed of agar/potato starch and anthocyanin extracts from purple sweet potato. Food Chem. 2017, 218, 122–128. [Google Scholar] [CrossRef]
- Alizadeh-Sani, M.; Mohammadian, E.; Rhim, J.-W.; Jafari, S.M. pH-sensitive (halochromic) smart packaging films based on natural food colorants for the monitoring of food quality and safety. Trends Food Sci. Technol. 2020, 105, 93–144. [Google Scholar] [CrossRef]
- Oladzadabbasabadi, N.; Nafchi, A.M.; Ghasemlou, M.; Ariffin, F.; Singh, Z.; Al-Hassan, A. Natural anthocyanins: Sources, extraction, characterization, and suitability for smart packaging. Food Packag. Shelf Life 2022, 33, 100872. [Google Scholar] [CrossRef]
- Roy, S.; Rhim, J.-W. Anthocyanin food colorant and its application in pH-responsive color change indicator films. Crit. Rev. Food Sci. Nutr. 2020, 61, 2297–2325. [Google Scholar] [CrossRef] [PubMed]
- Chen, M.; Yan, T.; Huang, J.; Zhou, Y.; Hu, Y. Fabrication of halochromic smart films by immobilizing red cabbage anthocyanins into chitosan/oxidized-chitin nanocrystals composites for real-time hairtail and shrimp freshness monitoring. Int. J. Biol. Macromol. 2021, 179, 90–100. [Google Scholar] [CrossRef]
- He, Y.; Li, B.; Du, J.; Cao, S.; Liu, M.; Li, X.; Ren, D.; Wu, X.; Xu, D. Development of pH-responsive absorbent pad based on polyvinyl alcohol/agarose/anthocyanins for meat packaging and freshness indication. Int. J. Biol. Macromol. 2022, 201, 203–215. [Google Scholar] [CrossRef]
- Azlim, N.A.; Nafchi, A.M.; Oladzadabbasabadi, N.; Ariffin, F.; Ghalambor, P.; Jafarzadeh, S.; Al-Hassan, A.A. Fabrication and characterization of a pH-sensitive intelligent film incorporating dragon fruit skin extract. Food Sci. Nutr. 2021, 10, 597–608. [Google Scholar] [CrossRef]
- Qin, Y.; Liu, Y.; Yong, H.; Liu, J.; Zhang, X.; Liu, J. Preparation and characterization of active and intelligent packaging films based on cassava starch and anthocyanins from Lycium ruthenicum Murr. Int. J. Biol. Macromol. 2019, 134, 80–90. [Google Scholar] [CrossRef]
- Suriyatem, R.; Auras, R.A.; Rachtanapun, P. Improvement of mechanical properties and thermal stability of biodegradable rice starch–based films blended with carboxymethyl chitosan. Ind. Crop. Prod. 2018, 122, 37–48. [Google Scholar] [CrossRef]
- Bilgiç, S.; Söğüt, E.; Seydim, A.C. Chitosan and Starch Based Intelligent Films with Anthocyanins from Eggplant to Monitor pH Variations. Turk. J. Agric.-Food Sci. Technol. 2019, 7, 61–66. [Google Scholar] [CrossRef]
- Manoel, A.F.; Claro, P.I.C.; Mattoso, L.H.C.; Marconcini, J.M.; Mantovani, G.L. Thermoplastic Waxy Starch Films Processed by Extrusion and Pressing: Effect of Glycerol and Water Concentration. Mater. Res. 2017, 20, 353–357. [Google Scholar] [CrossRef]
- Bao, Y.; Zhang, H.; Luan, Q.; Zheng, M.; Tang, H.; Huang, F. Fabrication of cellulose nanowhiskers reinforced chitosan-xylan nanocomposite films with antibacterial and antioxidant activities. Carbohydr. Polym. 2017, 184, 66–73. [Google Scholar] [CrossRef] [PubMed]
- Ma, Y.; Li, S.; Ji, T.; Wu, W.; Sameen, D.E.; Ahmed, S.; Qin, W.; Dai, J.; Liu, Y. Development and optimization of dynamic gelatin/chitosan nanoparticles incorporated with blueberry anthocyanins for milk freshness monitoring. Carbohydr. Polym. 2020, 247, 116738. [Google Scholar] [CrossRef] [PubMed]
- Jampani, C.; Raghavarao, K. Process integration for purification and concentration of red cabbage (Brassica oleracea L.) anthocyanins. Sep. Purif. Technol. 2015, 141, 10–16. [Google Scholar] [CrossRef]
- Alizadeh-Sani, M.; Tavassoli, M.; Mohammadian, E.; Ehsani, A.; Khaniki, G.J.; Priyadarshi, R.; Rhim, J.-W. pH-responsive color indicator films based on methylcellulose/chitosan nanofiber and barberry anthocyanins for real-time monitoring of meat freshness. Int. J. Biol. Macromol. 2020, 166, 741–750. [Google Scholar] [CrossRef]
- Zhang, K.; Huang, T.-S.; Yan, H.; Hu, X.; Ren, T. Novel pH-sensitive films based on starch/polyvinyl alcohol and food anthocyanins as a visual indicator of shrimp deterioration. Int. J. Biol. Macromol. 2019, 145, 768–776. [Google Scholar] [CrossRef]
- Dong, H.; Ling, Z.; Zhang, X.; Zhang, X.; Ramaswamy, S.; Xu, F. Smart colorimetric sensing films with high mechanical strength and hydrophobic properties for visual monitoring of shrimp and pork freshness. Sens. Actuators B Chem. 2020, 309, 127752. [Google Scholar] [CrossRef]
- Purbaningtias, T.E.; Aprilia, A.C.; Fauzi’Ah, L. The study of temperature and UV light effect in anthocyanin extract from dragon fruit (Hylocereus costaricensis) rind using UV-Visible spectrophotometer. AIP Conf. Proc. 2017, 1911, 020014. [Google Scholar] [CrossRef]
- Apriliyanti, M.W.; Wahyono, A.; Fatoni, M.; Poerwanto, B.; Suryaningsih, W. The Potency of betacyanins extract from a peel of dragon fruits as a source of colourimetric indicator to develop intelligent packaging for fish freshness monitoring. IOP Conf. Ser. Earth Environ. Sci. 2018, 207, 012038. [Google Scholar] [CrossRef]
- Filho, J.G.D.O.; Braga, A.R.C.; de Oliveira, B.R.; Gomes, F.P.; Moreira, V.L.; Pereira, V.A.C.; Egea, M.B. The potential of anthocyanins in smart, active, and bioactive eco-friendly polymer-based films: A review. Food Res. Int. 2021, 142, 110202. [Google Scholar] [CrossRef]
- Mujtaba, M.; Morsi, R.E.; Kerch, G.; Elsabee, M.Z.; Kaya, M.; Labidi, J.; Khawar, K.M. Current advancements in chitosan-based film production for food technology; A review. Int. J. Biol. Macromol. 2018, 121, 889–904. [Google Scholar] [CrossRef]
- Dang, K.M.; Yoksan, R. Development of thermoplastic starch blown film by incorporating plasticized chitosan. Carbohydr. Polym. 2015, 115, 575–581. [Google Scholar] [CrossRef] [PubMed]
- Priatni, S.; Pradita, A. Stability Study of Betacyanin Extract from Red Dragon Fruit (Hylocereus Polyrhizus) Peels. Procedia Chem. 2015, 16, 438–444. [Google Scholar] [CrossRef]
- Yong, H.; Liu, J.; Qin, Y.; Bai, R.; Zhang, X.; Liu, J. Antioxidant and pH-sensitive films developed by incorporating purple and black rice extracts into chitosan matrix. Int. J. Biol. Macromol. 2019, 137, 307–316. [Google Scholar] [CrossRef]
- Koosha, M.; Hamedi, S. Intelligent Chitosan/PVA nanocomposite films containing black carrot anthocyanin and bentonite nanoclays with improved mechanical, thermal and antibacterial properties. Prog. Org. Coat. 2019, 127, 338–347. [Google Scholar] [CrossRef]
- Dabadé, D.S.; den Besten, H.M.W.; Azokpota, P.; Nout, M.J.R.; Hounhouigan, D.J.; Zwietering, M.H. Spoilage evaluation, shelf-life prediction, and potential spoilage organisms of tropical brackish water shrimp (Penaeus notialis) at different storage temperatures. Food Microbiol. 2015, 48, 8–16. [Google Scholar] [CrossRef]
- Zhang, J.; Zou, X.; Zhai, X.; Huang, X.W.; Jiang, C.; Holmes, M. Preparation of an intelligent pH film based on biodegradable polymers and roselle anthocyanins for monitoring pork freshness. Food Chem. 2019, 272, 306–312. [Google Scholar] [CrossRef] [PubMed]
- Qin, Y.; Liu, Y.; Zhang, X.; Liu, J. Development of active and intelligent packaging by incorporating betalains from red pitaya (Hylocereus polyrhizus) peel into starch/polyvinyl alcohol films. Food Hydrocoll. 2020, 100, 105410. [Google Scholar] [CrossRef]
- Forghani, S.; Zeynali, F.; Almasi, H.; Hamishehkar, H. Characterization of electrospun nanofibers and solvent-casted films based on Centaurea arvensis anthocyanin-loaded PVA/κ-carrageenan and comparing their performance as colorimetric pH indicator. Food Chem. 2022, 388, 133057. [Google Scholar] [CrossRef]
- Yao, X.; Liu, J.; Hu, H.; Yun, D.; Liu, J. Development and comparison of different polysaccharide/PVA-based active/intelligent packaging films containing red pitaya betacyanins. Food Hydrocoll. 2022, 124, 107305. [Google Scholar] [CrossRef]
- Bangyekan, C.; Aht-Ong, D.; Srikulkit, K. Preparation and properties evaluation of chitosan-coated cassava starch films. Carbohydr. Polym. 2006, 63, 61–71. [Google Scholar] [CrossRef]
- Dai, L.; Zhang, J.; Cheng, F. Effects of starches from different botanical sources and modification methods on physicochemical properties of starch-based edible films. Int. J. Biol. Macromol. 2019, 132, 897–905. [Google Scholar] [CrossRef] [PubMed]
- Vinsova, J.; Vavrikova, E. Chitosan Derivatives with Antimicrobial, Antitumour and Antioxidant Activities—a Review. Curr. Pharm. Des. 2011, 17, 3596–3607. [Google Scholar] [CrossRef]
- Schreiber, S.B.; Bozell, J.J.; Hayes, D.G.; Zivanovic, S. Introduction of primary antioxidant activity to chitosan for application as a multifunctional food packaging material. Food Hydrocoll. 2013, 33, 207–214. [Google Scholar] [CrossRef]
- Ma, Y.; Feng, Y.; Diao, T.; Zeng, W.; Zuo, Y. Experimental and theoretical study on antioxidant activity of the four anthocyanins. J. Mol. Struct. 2020, 1204, 127509. [Google Scholar] [CrossRef]
- Coma, V.; Deschamps, A.; Martial-Gros, A. Bioactive Packaging Materials from Edible Chitosan Polymer—Antimicrobial Activity Assessment on Dairy-Related Contaminants. J. Food Sci. 2003, 68, 2788–2792. [Google Scholar] [CrossRef]
- Dutta, P.K.; Tripathi, S.; Mehrotra, G.K.; Dutta, J. Perspectives for chitosan based antimicrobial films in food applications. Food Chem. 2009, 114, 1173–1182. [Google Scholar] [CrossRef]
- Cisowska, A.; Wojnicz, D.; Hendrich, A.B. Anthocyanins as Antimicrobial Agents of Natural Plant Origin. Nat. Prod. Commun. 2011, 6, 149–156. [Google Scholar] [CrossRef]
- Valencia-Sullca, C.; Atarés, L.; Vargas, M.; Chiralt, A. Physical and Antimicrobial Properties of Compression-Molded Cassava Starch-Chitosan Films for Meat Preservation. Food Bioprocess Technol. 2018, 11, 1339–1349. [Google Scholar] [CrossRef]
- Ezati, P.; Rhim, J.-W. pH-responsive chitosan-based film incorporated with alizarin for intelligent packaging applications. Food Hydrocoll. 2019, 102, 105629. [Google Scholar] [CrossRef]
- Kang, S.; Wang, H.; Xia, L.; Chen, M.; Li, L.; Cheng, J.; Li, X.; Jiang, S. Colorimetric film based on polyvinyl alcohol/okra mucilage polysaccharide incorporated with rose anthocyanins for shrimp freshness monitoring. Carbohydr. Polym. 2019, 229, 115402. [Google Scholar] [CrossRef]

| Formulation | Chitosan 1% (w/v) (mL) | Cassava Starch 2% (w/v) (mL) | Glycerol 85% (mL) | Anthocyanin Extract (mL) |
|---|---|---|---|---|
| SChA | 7.46 | 7.46 | 0.08 | 5 |
| SCh | 9.96 | 9.96 | 0.08 | 0 |
| Ch | 19.92 | 0 | 0.08 | 0 |
| S | 0 | 19.92 | 0.08 | 0 |
| Film | Thickness (mm) | Tensile Strength (MPa) | Elongation at Break (%) | Young’s Modulus |
|---|---|---|---|---|
| SChA | 0.12 ± 0.00 d | 3.89 ± 0.15 a | 27.62 ± 0.57 b | 0.14 ± 0.01 a |
| SCh | 0.1 ± 0.01 c | 4.68 ± 0.31 b | 26.14 ± 0.92 b | 0.18 ± 0.00 b |
| Ch | 0.08 ± 0.00 b | 14.01 ± 0.44 d | 23.08 ± 0.76 a | 0.61 ± 0.00 d |
| S | 0.07 ± 0.00 a | 8.03 ± 0.3 c | 21.77 ± 1.58 a | 0.37 ± 0.03 c |
| Film | L* | a* | b* | ΔE |
|---|---|---|---|---|
| SChA | 40.07 ± 0.91 a | 38.8 ± 1.07 d | 7.33 ± 1.14 b | 66.24 ± 1.24 d |
| SCh | 79.57 ± 0.24 c | 1.39 ± 0.09 b | 6.58 ± 0.02 b | 14.84 ± 0.39 b |
| Ch | 76.97 ± 0.34 b | 2.76 ± 0.16 c | 12.14 ± 0.46 c | 19.73 ± 0.13 c |
| S | 81.91 ± 0.26 d | 0.78 ± 0.04 a | −1.8 ± 0.05 a | 12.06 ± 0.24 a |
| Film | Transparency (log T600/mm) |
|---|---|
| SChA | 11.89 ± 0.54 a |
| SCh | 14.53 ± 0.63 b |
| Ch | 36.04 ± 1.19 c |
| S | 10.65 ± 0.17 a |
| Film | Antioxidant Activity (%) |
|---|---|
| SChA | 4.90 ± 0.08 c |
| SCh | 2.52 ± 0.22 a |
| Ch | 4.46 ± 0.08 b |
| S | - |
Publisher’s Note: MDPI stays neutral with regard to jurisdictional claims in published maps and institutional affiliations. |
© 2022 by the authors. Licensee MDPI, Basel, Switzerland. This article is an open access article distributed under the terms and conditions of the Creative Commons Attribution (CC BY) license (https://creativecommons.org/licenses/by/4.0/).
Share and Cite
Pramitasari, R.; Gunawicahya, L.N.; Anugrah, D.S.B. Development of an Indicator Film Based on Cassava Starch–Chitosan Incorporated with Red Dragon Fruit Peel Anthocyanin Extract. Polymers 2022, 14, 4142. https://doi.org/10.3390/polym14194142
Pramitasari R, Gunawicahya LN, Anugrah DSB. Development of an Indicator Film Based on Cassava Starch–Chitosan Incorporated with Red Dragon Fruit Peel Anthocyanin Extract. Polymers. 2022; 14(19):4142. https://doi.org/10.3390/polym14194142
Chicago/Turabian StylePramitasari, Rianita, Levina Natasha Gunawicahya, and Daru Seto Bagus Anugrah. 2022. "Development of an Indicator Film Based on Cassava Starch–Chitosan Incorporated with Red Dragon Fruit Peel Anthocyanin Extract" Polymers 14, no. 19: 4142. https://doi.org/10.3390/polym14194142
APA StylePramitasari, R., Gunawicahya, L. N., & Anugrah, D. S. B. (2022). Development of an Indicator Film Based on Cassava Starch–Chitosan Incorporated with Red Dragon Fruit Peel Anthocyanin Extract. Polymers, 14(19), 4142. https://doi.org/10.3390/polym14194142

